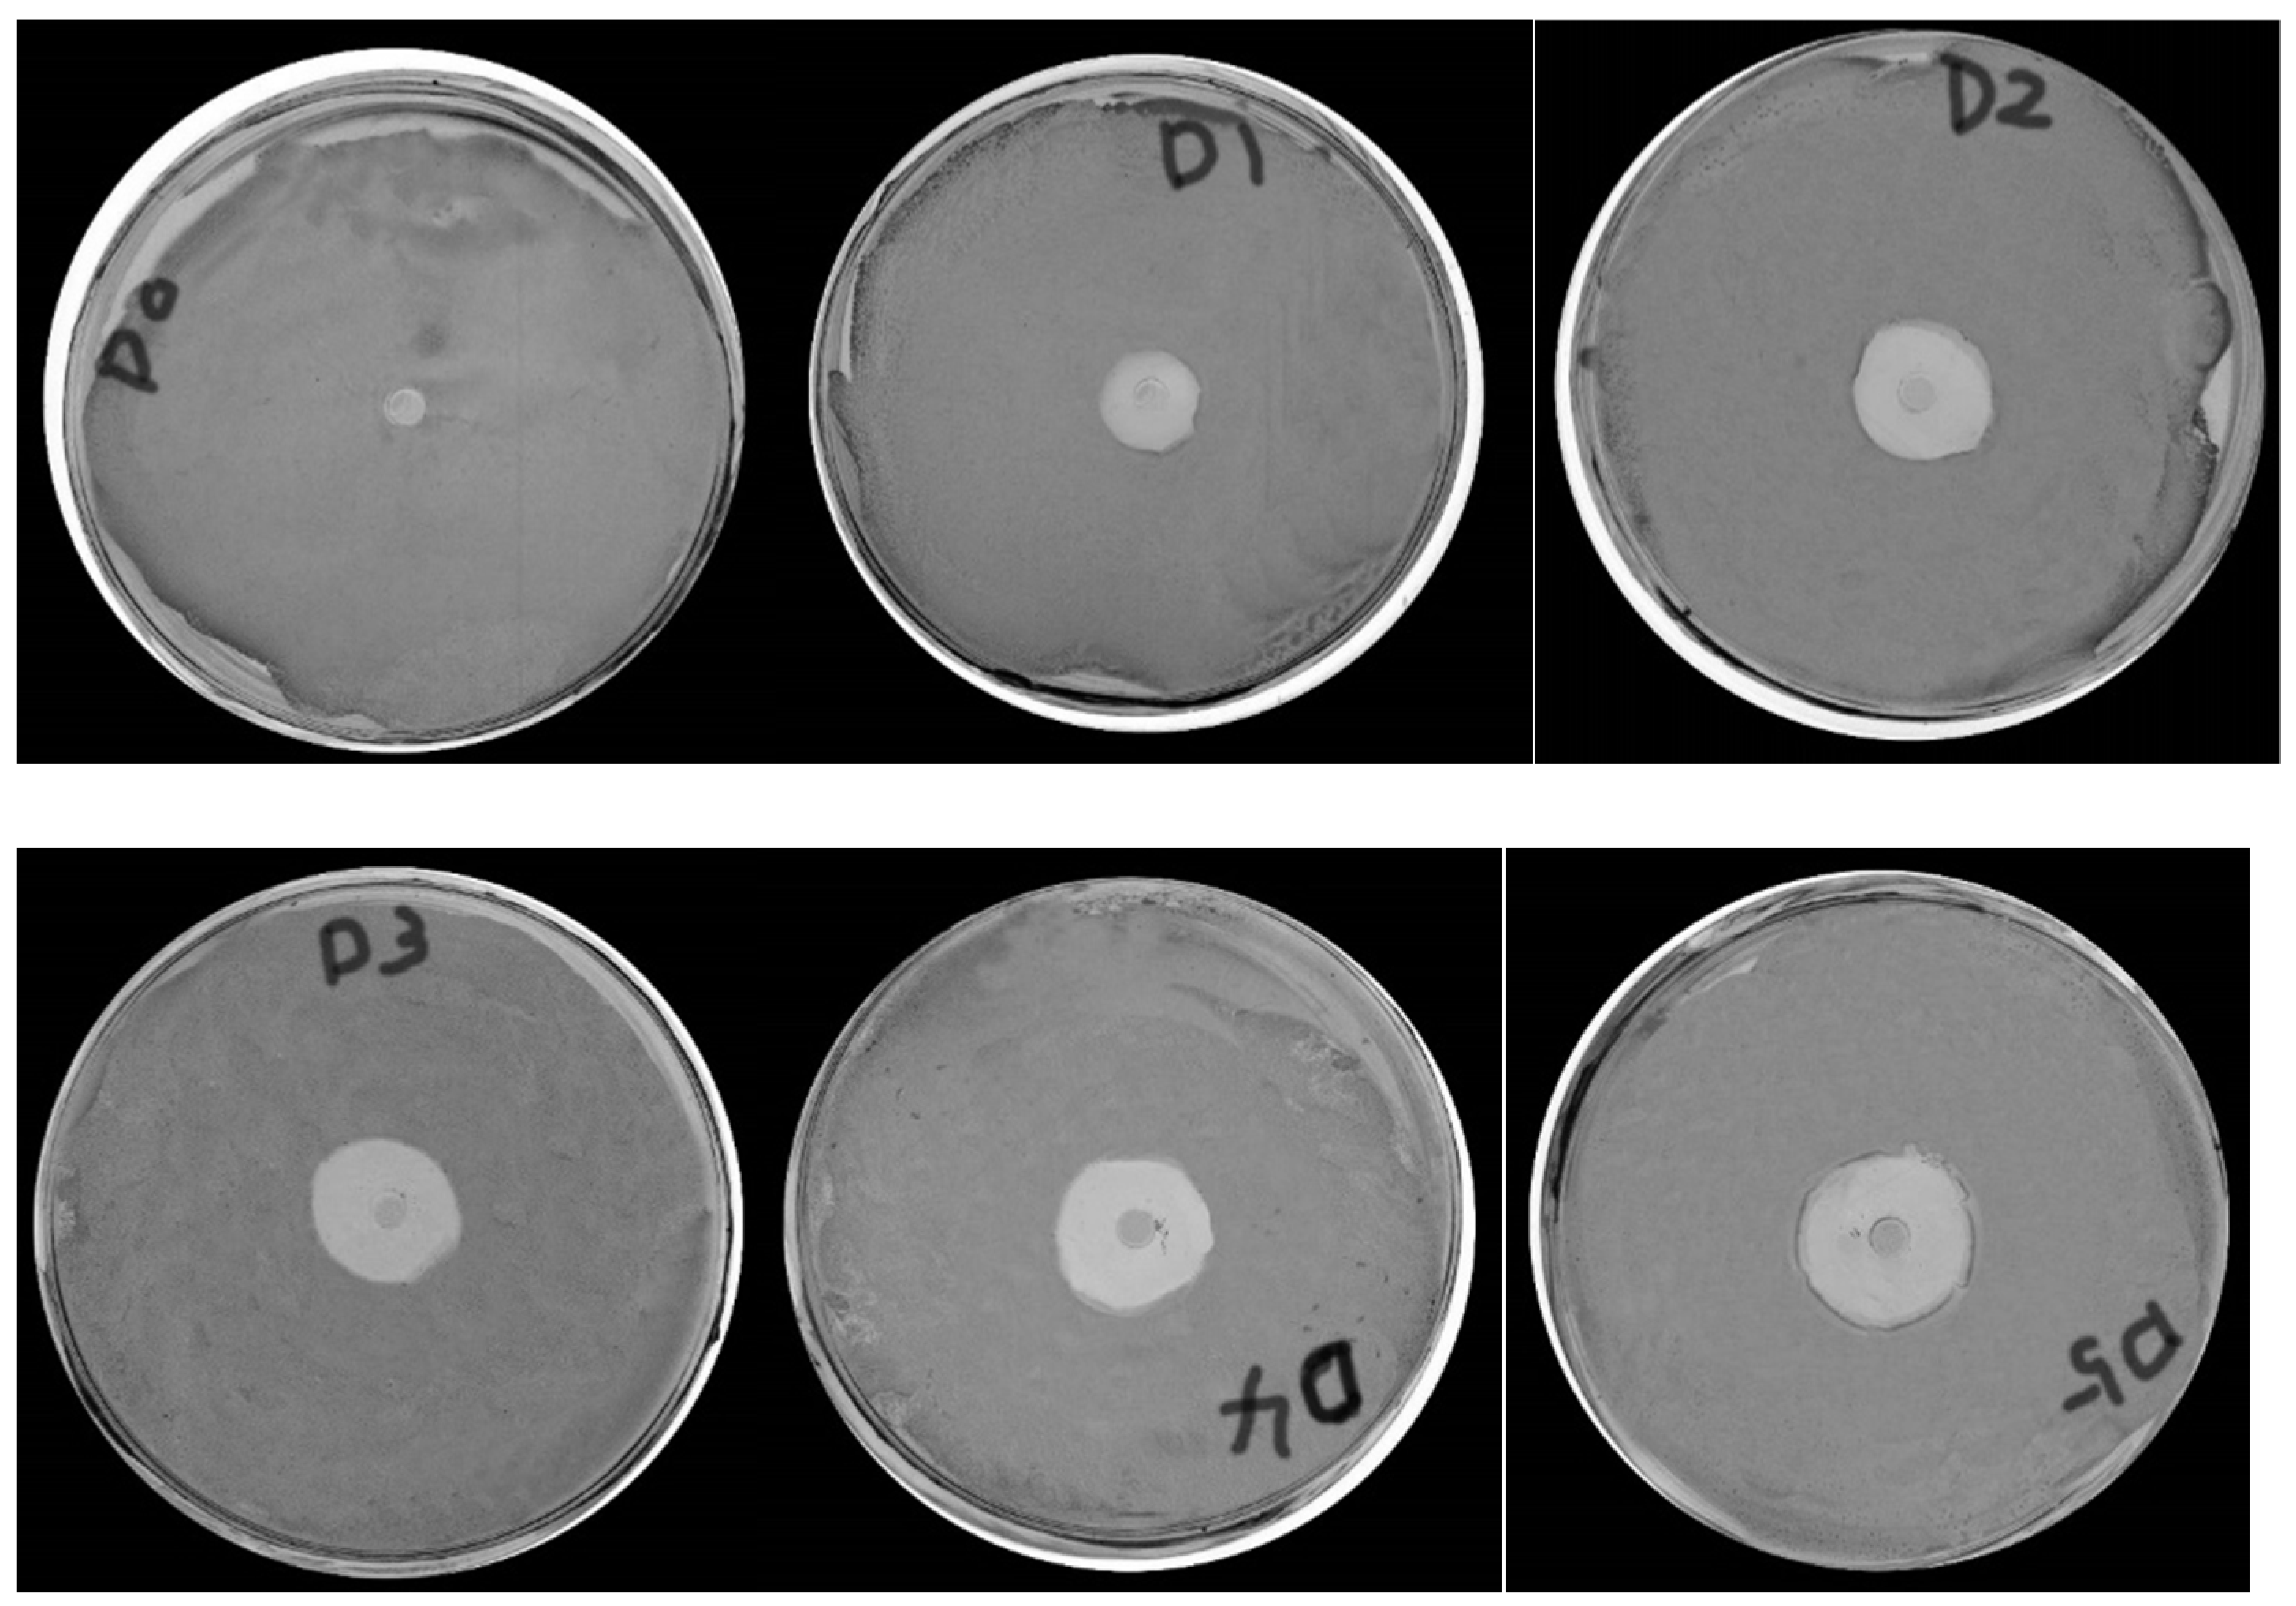
Polymers 14 00213 g007
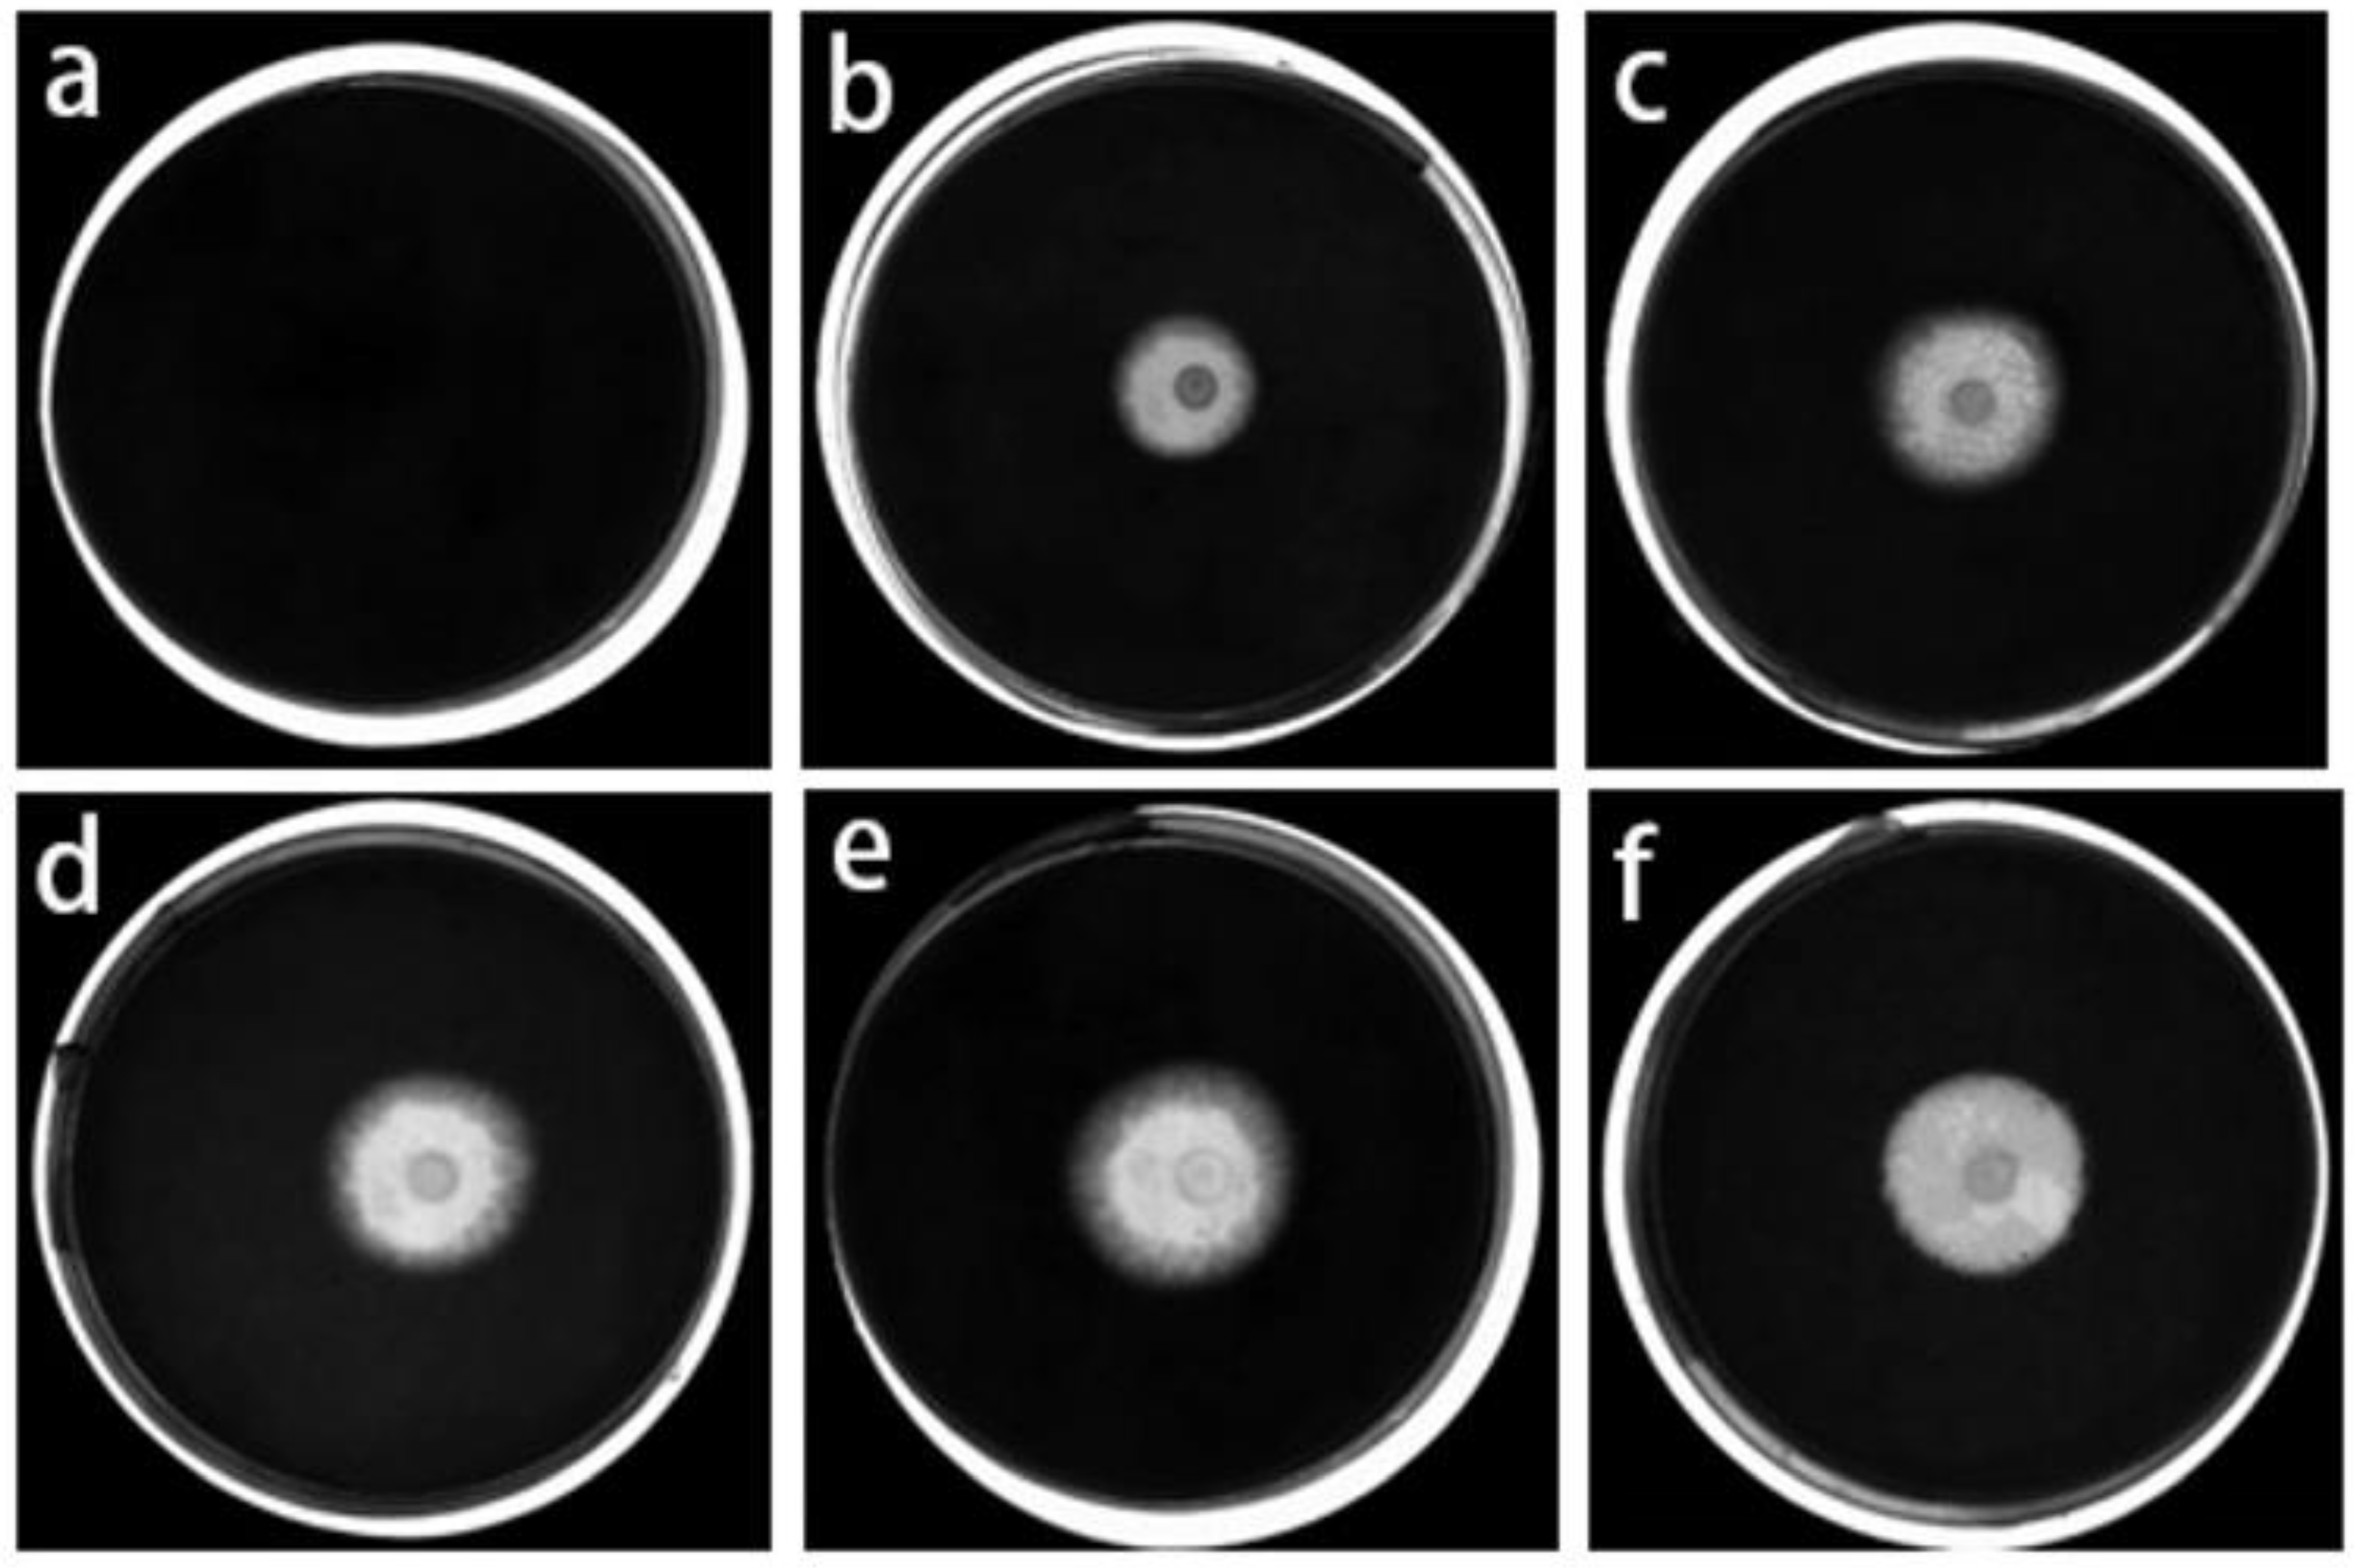
Polymers 14 00213 g010

Synthesis, Characterization and Properties of Antibacterial Polyurethanes †
Abstract
:1. Introduction
2. Experimental Methods
2.1. Materials
2.2. Preparation of PUII
2.3. Preparation of PUII with Antibacterial Agent
2.4. Characterization
2.5. Barrier Properties Experiment
3. Results and Discussion
3.1. Synthesis of PUII
3.2. Self-Assembly Behavior of PUII
3.3. Barrier Properties of PUII
3.4. Mechanical Properties and Thermal Analysis of PUII
3.5. Antimicrobial Properties
4. Conclusions
Author Contributions
Funding
Institutional Review Board Statement
Informed Consent Statement
Data Availability Statement
Acknowledgments
Conflicts of Interest
References
- Xia, Y.; Zhang, Z.Y.; Kessler, M.R.; Stecher, B.B.; Larock, R.C. Antibacterial soybean-Oil-based cationic polyurethane coatings prepared from different amino polyols. ChemSusChem 2012, 5, 2221–2227. [Google Scholar] [CrossRef]
- Akindoyo, J.O.; Beg, M.D.H.; Ghazali, S.; Islam, M.R.; Jeyaratnam, N.; Yuvaraj, A.R. Polyurethane types, synthesis and applications. RSC Adv. 2016, 6, 114453–114482. [Google Scholar] [CrossRef] [Green Version]
- Engels, H.W.; Pirkl, H.G.; Albers, R.; Albach, R.W.; Krause, J.; Hoffmann, A.; Casselmann, H.; Dormish, J. Polyurethanes: Versatile materials and sustainable problem solvers for today’s challenges. Angew. Chem. Int. Ed. 2013, 52, 9422–9441. [Google Scholar] [CrossRef]
- Zhang, Z.P.; Rong, M.Z.; Zhang, M.Q. Polymer engineering based on reversible covalent chemistry: A promising innovative pathway towards new materials and new functionalities. Prog. Polym. Sci. 2018, 80, 39–93. [Google Scholar] [CrossRef]
- Scheutz, G.M.; Lessard, J.J.; Sims, M.B.; Sumerlin, B.S. Adaptable crosslinks in polymeric materials: Resolving the intersection of thermoplastics and thermosets. J. Am. Chem. Soc. 2019, 141, 16181–16196. [Google Scholar] [CrossRef]
- Zee, N.J.V.; Nicolaÿ, R. Vitrimers: Permanently cross-linked polymers with dynamic network topology. Prog. Polym. Sci. 2020, 7, 30–38. [Google Scholar]
- Nevejans, S.; Ballard, N.; Fernández, M.; Reck, B.; Asua, J.M. Flexible aromatic disulfide monomers for high-performance self-healable linear and cross-linked poly(urethane-urea) coatings. Polymer 2019, 166, 229–238. [Google Scholar] [CrossRef]
- Zhang, J.; Shen, H.Z.; Zhang, X.; Li, H.Y. Experimental and theoretical investigation of mechanical behavior related to temperature, humidity and strain rate on silane-modified polyurethane sealant. Polym. Test. 2021, 103, 107370. [Google Scholar] [CrossRef]
- Behera, P.K.; Mondal, P.; Singha, N.K. Self-healable and ultrahydrophobic polyurethane-poss hybrids by diels-alder “click” reaction: A new class of coating material. Macromolecules 2018, 51, 4770–4781. [Google Scholar] [CrossRef]
- Gao, Z.; Peng, J.; Zhong, T.; Sun, J.; Wang, X.; Yue, C. Biocompatible elastomer of waterborne polyurethane based on castor oil and polyethylene glycol with cellulose nanocrystals. Carbohydr. Polym. 2012, 87, 2068–2075. [Google Scholar] [CrossRef]
- Chen, J.; Hu, D.; Li, Y.; Zhu, J.; Du, A.; Zeng, J. Castor oil-based high performance and reprocessable poly(urethane urea) network. Polym. Test. 2018, 70, 174–179. [Google Scholar] [CrossRef]
- Rangamani, A.; Alabi, C.A. Effect of backbone and end-group regioisomerism on thermomechanical properties of vanillin-based polyurethane networks. Polym. Chem. 2021, 12, 1526–1532. [Google Scholar] [CrossRef]
- Liu, W.; Fang, C.; Wang, S.; Huang, J.; Qiu, X. High-performance lignin-containing polyurethane elastomers with dynamic covalent polymer networks. Macromolecules 2019, 52, 6474–6480. [Google Scholar] [CrossRef]
- Ma, X.; Chen, J.; Zhu, J.; Yan, N. Lignin-based polyurethane: Recent advances and future perspectives. Macromol. Rapid Commun. 2021, 42, 2000492. [Google Scholar] [CrossRef] [PubMed]
- Lee, S.-H.; Shin, S.-R.; Lee, D.-S. Self-healing of cross-linked PU via dual-dynamic covalent bonds of a Schiff base from cystine and vanillin. Mater. Des. 2019, 172, 107774. [Google Scholar] [CrossRef]
- Zheng, N.; Fang, Z.; Zou, W.; Zhao, Q.; Xie, T. Thermoset shape-memory polyurethane with intrinsic plasticity enabled by transcarbamoylation. Angew. Chem. Int. Ed. 2016, 55, 11421–11425. [Google Scholar] [CrossRef]
- Li, C.Y.; Chen, J.H.; Chien, P.C.; Chiu, W.Y.; Chen, R.S.; Don, T.M. Preparation of poly (IPDI-PTMO-siloxanes) and influence of siloxane structure on reactivity and mechanical properties. Polym. Eng. Sci. 2007, 47, 625–632. [Google Scholar] [CrossRef]
- Mishra, A.; Singh, S.K.; Dash, D.; Aswal, V.K.; Maiti, B.; Misra, M.; Maiti, P. Self-assembled aliphatic chain extended polyurethane nanobiohybrids: Emerging hemocompatible biomaterials for sustained drug delivery. Acta Biomater. 2014, 10, 2133–2146. [Google Scholar] [CrossRef]
- Andreas, L.; Robert, L. Biodegradable, elastic shape-memory polymers for potential biomedical applications. Science 2002, 296, 1673–1676. [Google Scholar]
- Madbouly, S.A.; Otaigbe, J.U. Recent advances in synthesis, characterization and rheological properties of polyurethanes and POSS/polyurethane nanocomposites dispersions and films. Prog. Polym. Sci. 2009, 34, 1283–1332. [Google Scholar] [CrossRef]
- Zhang, Y.; Wang, L.; Zhang, Z.; Zhang, Y.; Tuo, X. Synthesis and simultaneous self-assembly of multiblock fluorinated polyurethane in iniferter polymerization. J. Polym. Sci. Part A Polym. Chem. 2013, 51, 2161–2170. [Google Scholar] [CrossRef]
- Rogulska, M.; Kultys, A.; Podkoscielny, W. Studies on thermoplastic polyurethanes based on new diphenylethane-derivative diols. II. Synthesis and characterization of segmented polyurethanes from HDI and MDI. Eur. Polym. J. 2007, 43, 1402–1414. [Google Scholar] [CrossRef]
- Singh, R.P.; Tomer, N.S.; Bhadraiah, S.V. Photo-oxidation studies on polyurethane coating: Effect of additives on yellowing of polyurethane. Polym. Degrad. Stab. 2001, 73, 443–446. [Google Scholar] [CrossRef]
- Thapliyal, B.P.; Chandra, R. Advances in photodegradation and stabilization of polyurethanes. Prog. Polym. Sci. 1990, 15, 735–750. [Google Scholar] [CrossRef]
- Desai, S.D.; Emanuel, A.L.; Sinha, V.K. Polyester polyol based polyurethane adhesive: Effect of treatment on rubber surface. J. Polym. Res. 2003, 10, 141–149. [Google Scholar] [CrossRef]
- Chen, C.J. Waterborne polyurethane adhesive and its application in dry compound. Plastics Packag. 2007, 17, 50–54. [Google Scholar]
- Zhukova, E.E.; Shtilman, M.I.; Iordanskii, A.L. Polyurethane films with antimicrobial properties, intended for the development of coatings preventing catheter-associated bloodstream infections. Int. Polym. Sci. Technol. 2013, 40, 51–55. [Google Scholar] [CrossRef]
- Mohammadi, A.; Doctorsafaei, A.H.; Burujeny, S.B.; Rudbari, H.A.; Kordestani, N.; Najafabadi, S.A.A. Silver(I) complex with a Schiff base ligand extended waterborne polyurethane: A developed strategy to obtain a highly stable antibacterial dispersion impregnated with in situ formed silver nanoparticles. Chem. Eng. J. 2021, 381, 122776. [Google Scholar] [CrossRef]
- Liu, K.; Su, Z.G.; Miao, S.D.; Ma, G.H.; Zhang, S.P. UV-curable enzymatic antibacterial waterborne polyurethane coating. Biochem. Eng. J. 2016, 113, 107–113. [Google Scholar] [CrossRef]
- Muzaffar, S.; Bhatti, I.A.; Zuber, M.; Bhatti, H.N.; Shahid, M. Study of the UV protective and antibacterial properties of aqueous polyurethane dispersions extended with low molecular weight chitosan. Int. J. Biol. Macromol. 2017, 94, 51–60. [Google Scholar] [CrossRef] [PubMed]
- Jiang, G.C.; Tuo, X.L.; Wang, D.R.; Li, Q. Synthesis and properties novel polyurethane-hexafluorobutyl methacrylate copolymers. J. Mater. Sci. Mater. Med. 2012, 23, 1867–1877. [Google Scholar] [CrossRef] [PubMed]
- Marsat, J.N.; Heydenreich, M.; Kleinpeter, E.; Berlepsch, H.V.; BooTtcher, C.; Laschewsky, A. Self-Assembly into Multicompartment Micelles and Selective Solubilization by Hydrophilic− Lipophilic− Fluorophilic Block Copolymers. Macromolecules 2011, 44, 2092–2105. [Google Scholar] [CrossRef]
- Jenekhe, S.A.; Chen, X.L. Self-assembly of ordered microporous materials from rod-coil block copolymers. Science 1999, 283, 372–375. [Google Scholar] [CrossRef]
- Li, X.M.; He, J.D. Studies on Amphiphilic Triblock Copolymer PHB-PEG-PHB and Its Nanoparticles. Acta Polym. Sin. 2015, 1, 41–48. [Google Scholar]
- Winey, K.I.; Thomas, E.L.; Fetters, L.J. Ordered morphologies in binary blends of diblock copolymer and homopolymer and characterization of their intermaterial dividing surfaces. J. Chem. Phys. 1991, 95, 9367–9375. [Google Scholar] [CrossRef]
- Li, Z.; Hillmyer, M.A.; Lodge, T.P. Morphologies of multicompartment micelles formed by ABC miktoarm star terpolymers. Langmuir 2006, 22, 9409–9417. [Google Scholar] [CrossRef]
- Amundson, K.; Helfand, E.; Davis, D.D.; Quan, X.; Patel, S.S.; Smith, S.D. Effect of an electric field on block copolymer microstructure. Macromolecules 1991, 24, 6546–6548. [Google Scholar] [CrossRef]
- Xu, T.; Goldbach, J.T.; Russell, T.P. Sequential, orthogonal fields: A path to long-range, 3-D order in block copolymer thin films. Macromolecules 2003, 36, 7296–7300. [Google Scholar] [CrossRef]
- Wang, B.; Fan, Y.-L.; Jiang, G.-C.; Liu, J.-Y. Preparation and Characterization of New Antibacterial Polyurethane Packaging Film. Packag. Eng. 2021, 42, 155–161. [Google Scholar]

| The Content of Antibacterial Agent (%) | Transmittance (%) | Haze (%) |
|---|---|---|
| 0 | 89.7 | 51.11 |
| 0.2 | 73.5 | 90.23 |
| 0.4 | 70.2 | 90.31 |
| 0.6 | 66.3 | 91.22 |
| 0.8 | 62.8 | 92.13 |
| 1.0 | 61.1 | 92.91 |
| The Content of Antibacterial Agent (%) | Breaking Elongation (%) | Tensile Strength (MPa) |
|---|---|---|
| 0 ave. a | 502.7 ± 40.1 | 41.1 ± 3.2 |
| 0.2 ave. | 519.9 ± 43.2 | 42.3 ± 3.5 |
| 0.4 ave. | 528.8 ± 47.5 | 43.5 ± 4.2 |
| 0.6 ave. | 539.6 ± 45.3 | 44.2 ± 3.8 |
| 0.8 ave. | 557.8 ± 48.6 | 45.1 ± 5.2 |
| 1.0 ave. | 581.9 ± 52.8 | 46.9 ± 4.7 |
| The Content of Antibacterial Agent/% | The Antibacterial Circle Diameter/mm | |||
|---|---|---|---|---|
| Escherichia coli | Staphylococcus aureus | Bacillus subtilis | Gray mold | |
| 0 | 0 | 0 | 0 | 0 |
| 0.2 | 14.1 | 10.2 | 10.3 | 17.8 |
| 0.4 | 18.1 | 11.7 | 11.9 | 18.5 |
| 0.6 | 19.3 | 18.3 | 13.8 | 19.1 |
| 0.8 | 20.9 | 21.9 | 15.5 | 19.9 |
| 1.0 | 23.2 | 22.1 | 17.1 | 22.2 |
Publisher’s Note: MDPI stays neutral with regard to jurisdictional claims in published maps and institutional affiliations. |
© 2022 by the authors. Licensee MDPI, Basel, Switzerland. This article is an open access article distributed under the terms and conditions of the Creative Commons Attribution (CC BY) license (https://creativecommons.org/licenses/by/4.0/).
Share and Cite
Duan, J.; Jiang, G. Synthesis, Characterization and Properties of Antibacterial Polyurethanes. Polymers 2022, 14, 213. https://doi.org/10.3390/polym14010213
Duan J, Jiang G. Synthesis, Characterization and Properties of Antibacterial Polyurethanes. Polymers. 2022; 14(1):213. https://doi.org/10.3390/polym14010213
Chicago/Turabian StyleDuan, Jihua, and Guichang Jiang. 2022. "Synthesis, Characterization and Properties of Antibacterial Polyurethanes" Polymers 14, no. 1: 213. https://doi.org/10.3390/polym14010213
APA StyleDuan, J., & Jiang, G. (2022). Synthesis, Characterization and Properties of Antibacterial Polyurethanes. Polymers, 14(1), 213. https://doi.org/10.3390/polym14010213
